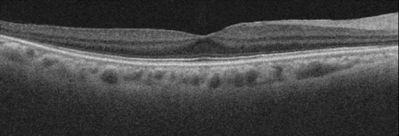
正常眼のOCT画像
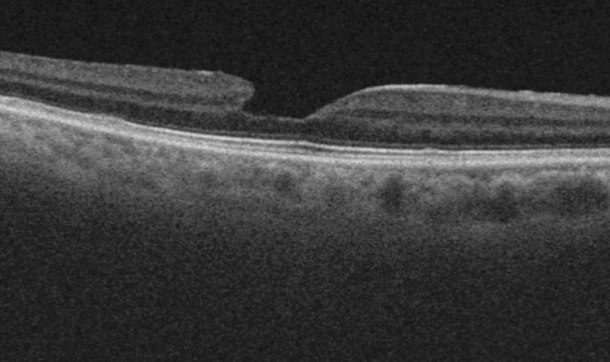
黄斑偽円孔OCT

黄斑前膜とは?

黄斑前膜とは、網膜の中心にある黄斑に、セロファンのような薄い膜が形成される病気です。
膜が縮んでくると、網膜にしわができます。
加齢によってできるものがほとんどですが、網膜剥離手術や光凝固のあとなどにできる続発性のものもあります。

原因
眼の中には硝子体という、水晶体と網膜の間の空間を満たすゼリー状の物質でが存在します。加齢とともに硝子体が液体に変化し網膜から剥がれます。(後部硝子体剥離)(図1)後部硝子体剥離が起こったとき、硝子体と黄斑の癒着が強いとうまくはがれず、黄斑に残った硝子体を基にして、黄斑前膜ができます。(図2)


症状
- 物が歪んで見える
- 大きく見える(大師視症)
- かすんで見える

治療
視力が良好で、自覚症状も少なく、日常生活や仕事に支障のない方は、手術を行わず経過観察することもあります。
視力が低下したり、歪みなどの症状が強いときは手術をします。
硝子体手術は、白目に小さな穴を開けて、硝子体を取り除いた後に、網膜の表面に張り付いている黄斑前膜をピンセットで丁寧に取り除きます。すでに白内障も進んでいる場合は、白内障手術も同時にすることができます。
黄斑前膜になったら
通常は失明の危険は少なく、慌てる必要はありません。
状態が悪くなっていないか、3か月、6か月ごとに眼科で眼底チェックを受ける必要があります。


硝子体手術を受ける場合は、硝子体手術を得意とする病院にご紹介いたします。
黄斑偽円孔とは?
黄斑前膜の一つに偽円孔というタイプがあります。黄斑の中心を除く黄斑の周りに前膜ができ、前膜の部分が収縮して盛り上がったために、中心が凹んで見えるようになった状態です。あたかも黄斑円孔のように見えるため偽円孔と呼ばれています。
症状
中心は正常なため自覚症状はほとんどありません。健診などで偶然見ることがほとんどです。
治療
物が歪む、視力が下がった場合、黄斑前膜と同じように手術します。

黄斑前膜よくある質問
手術のタイミングは?
視力の低下が著しい場合やゆがみが強くなったら、手術をお勧めしています。
急いで手術をしなければならないということはありません。時期を選ぶ時間はあります。
しかし視力がかなり低下してしまってからの手術では、視力が回復しないことがあります。
手術後の視力はどのくらいかかりますか?
中心窩の組織が修復されてゆっくりと視力も回復します。3-6か月くらいです。
手術すると歪みは消えますか?
電撃的にはよくなりません。時間はかかりますが(3-6か月)がすこしずつ歪みは減り、視力も上がることが多いです。